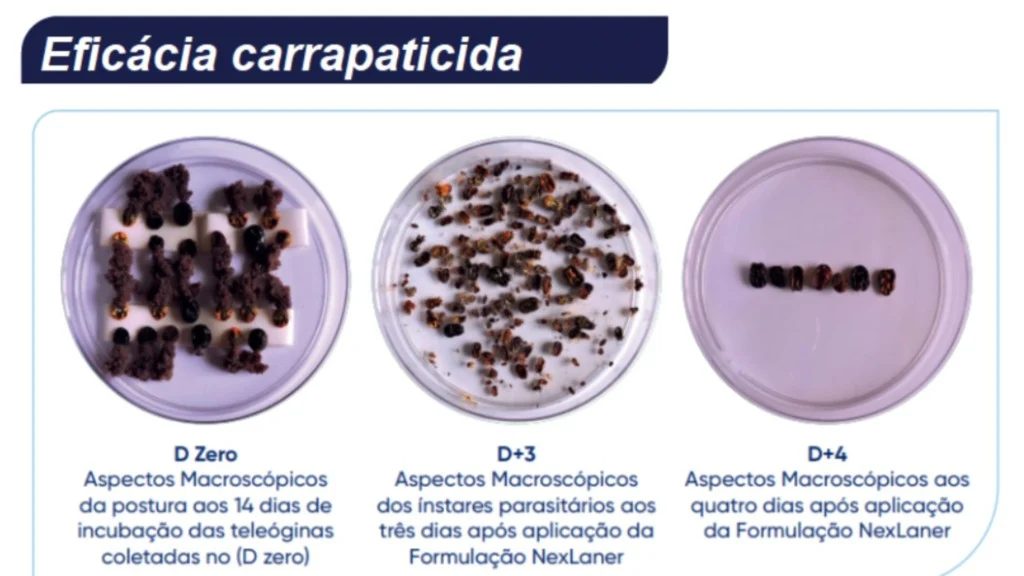
Nova solução contra carrapatos bovinos promete eliminar o parasita em até 72 horas

Produto da Ourofino à base de fluralaner promete eliminar a infestação em até 72 horas e oferece ação eficaz também contra bernes, bicheiras e moscas-dos-chifres
O carrapato bovino segue como um dos maiores desafios sanitários da pecuária nacional. Presente em praticamente todos os sistemas de criação no Brasil, esse pequeno parasita causa enormes prejuízos à produção de carne e leite, além de comprometer o desempenho e o bem-estar dos animais. Mas uma inovação tecnológica promete virar o jogo contra essa praga persistente.
Apresentado recentemente ao mercado, o Nexter é o nome da nova arma contra os carrapatos. O produto foi desenvolvido com base em fluralaner 2,5% e já mostra resultados impressionantes: elimina até os casos mais resistentes de infestação em no máximo 72 horas. Em muitos animais, os parasitas desaparecem completamente em apenas um dia, conforme destaca o médico-veterinário Fernando Dambrós, gerente de marketing da Ourofino Saúde Animal.
Ação imediata e proteção prolongada
Mais do que um simples tratamento, o Nexter inaugura um conceito diferente de controle parasitário: o chamado “efeito reset”. A proposta é interromper todo o ciclo de vida do carrapato — dos ovos às formas adultas — com uma única aplicação. Cada dose é ajustada ao peso do animal, na proporção de 1 mL para cada 10 kg, proporcionando um efeito de choque imediato e uma proteção duradoura por até 45 dias.
“O produto atua como ovicida, larvicida, ninficida e adulticida. Ou seja, atua em todas as fases do parasita e impede a reprodução dos sobreviventes”, explicou Dambrós em entrevista ao programa Giro do Boi. Segundo ele, o impacto dessa nova abordagem pode ser especialmente estratégico durante o inverno, quando as infestações costumam parecer menores, mas os parasitas mais resistentes ainda estão ativos.

Saúde animal é sinônimo de produtividade
Os efeitos dos carrapatos vão além da aparência dos animais. A infestação afeta diretamente o ganho de peso e o aproveitamento nutricional da dieta. Em um rebanho de mil animais, estima-se uma perda de até 30 toneladas de carne por ano causada apenas pela presença desses parasitas.
“Investir na sanidade do rebanho é garantir retorno. Animais saudáveis transformam melhor a ração em arrobas e atingem o ponto de abate com mais precocidade e qualidade”, reforça o veterinário.
Tratamento estratégico e custo acessível

O Nexter também se destaca pelo custo-benefício. Enquanto produtos tradicionais exigem reaplicações constantes, muitas vezes a cada duas semanas, o novo medicamento reduz drasticamente a necessidade de manejos frequentes — o que também diminui o estresse no rebanho e os custos indiretos com mão de obra.
A Ourofino recomenda o uso integrado do Nexter dentro de um plano chamado “Protocolo 360”. A proposta é alternar princípios ativos ao longo do ano para evitar que os parasitas desenvolvam resistência, especialmente em regiões com alta pressão de infestação.
Em alguns casos, o uso pode chegar a duas ou três aplicações anuais, sempre de forma estratégica e em alternância com outros produtos do portfólio da empresa.
Versatilidade contra diversas ameaças
Outro ponto forte do Nexter é sua ação ampliada: o produto combate não só os carrapatos, mas também bernes, bicheiras e moscas do chifre — pragas que igualmente causam dor de cabeça aos pecuaristas. Embora ainda não seja indicado para vacas em lactação, pode ser usado em novilhas e vacas secas, especialmente nos períodos mais críticos do ano.
Com um período de carência de apenas 24 dias, ele também é uma alternativa viável para uso em animais confinados, desde que o tempo mínimo antes do abate seja respeitado.

“O Nexter chega como uma solução completa: elimina rapidamente os parasitas, mantém os animais protegidos por semanas e tem aplicação simples e eficiente. É um avanço que muda o patamar do controle sanitário na pecuária brasileira”, finaliza Dambrós.
Escrito por Compre Rural
VEJA MAIS:
- A atuação do médico-veterinário na segurança dos alimentos
- Golpe milionário com ‘vaca virtual’ abala um dos maiores produtores de gado do mundo
ℹ️ Conteúdo publicado pela estagiária Ana Gusmão sob a supervisão do editor-chefe Thiago Pereira
Quer ficar por dentro do agronegócio brasileiro e receber as principais notícias do setor em primeira mão? Para isso é só entrar em nosso grupo do WhatsApp (clique aqui) ou Telegram (clique aqui). Você também pode assinar nosso feed pelo Google Notícias
Não é permitida a cópia integral do conteúdo acima. A reprodução parcial é autorizada apenas na forma de citação e com link para o conteúdo na íntegra. Plágio é crime de acordo com a Lei 9610/98.